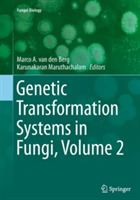
ibs

Genetic Transformation Systems in Fungi, Volume 2
Fungi are an economic very important class of microbes. Not only do they host a range of versatile enzymes used in industrial applications (biofuels, laundry, food processing), as well do they produce several very important pharmaceutical drugs (statins and penicillins). Moreover, fungal pathogens can cause great damage in agricultural production (Phytophthora and Botrytis) and during mammalian infections (Penicillium marneffei and Candida). Transformation of DNA is used to understand the genetic basis behind these traits. Several different techniques have been developed over the years and readily shown to be decisive methods to improve fungal biotechnology. This book will cover the basics behind the most commonly used transformation methods, as well as associated tools and techniques. Each chapter will provide protocols along with examples to be used in laboratories worldwide.
-
Curatore:
-
Editore:
-
Collana:Fungal Biology
-
Anno:2016
-
Rilegatura:Paperback / softback
Le schede prodotto sono aggiornate in conformità al Regolamento UE 988/2023. Laddove ci fossero taluni dati non disponibili per ragioni indipendenti da Feltrinelli, vi informiamo che stiamo compiendo ogni ragionevole sforzo per inserirli. Vi invitiamo a controllare periodicamente il sito www.lafeltrinelli.it per eventuali novità e aggiornamenti.
Per le vendite di prodotti da terze parti, ciascun venditore si assume la piena e diretta responsabilità per la commercializzazione del prodotto e per la sua conformità al Regolamento UE 988/2023, nonché alle normative nazionali ed europee vigenti.
Per informazioni sulla sicurezza dei prodotti, contattare productsafety@feltrinelli.it